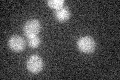
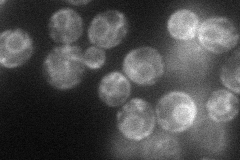
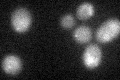
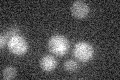

View description
Serine-threonine kinase and endoribonuclease; transmembrane protein that mediates the unfolded protein response (UPR) by regulating Hac1p synthesis through HAC1 mRNA splicing; Kar2p binds inactive Ire1p and releases from it upon ER stress
Localization:
Intensity:
Fold change:
Significance:
-
C’ GFP library in SD
below threshold14.35 -
N' NOP1pr-GFP in SD
ER55.8015 -
N' TEF2pr-mCherry in SD

ER30.9263 -
N' NATIVEpr-GFP in SD

below threshold21.4465 -
N' TEF2pr-VC and Cyto-VN in SD

#N/A0 -
C’ GFP library in SD+DTT
cytosol171.18No -
C’ GFP library in SD+H2O2

cytosol15.121.05No -
C’ GFP library in Starvation Media
cytosol16.621.15No -
C’ GFP library on the background of Pup2-DaMP

below threshold -
C’ GFP library on the background of CCT mutant

below threshold14.47531.00816No
